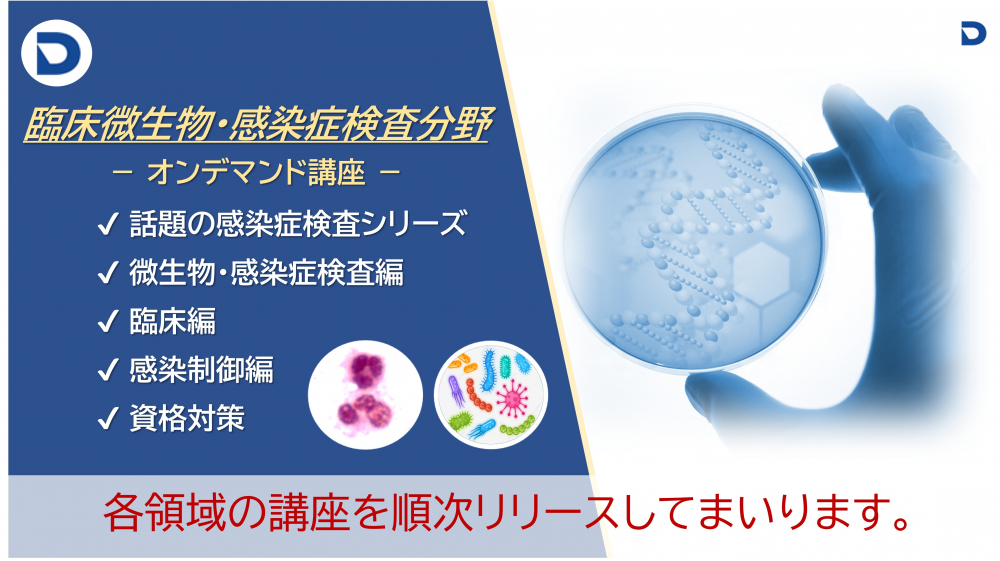
New：微生物検査分野　　　　　　　
【オンデマンド・動画講座一覧】

技術・知識・経験で繋げる
未来への可能性
医療・健康社会の未来を担う人財育成のサポートが私たちの役割です。



わたしたちについて ABOUT
国内オピニオンリーダーが集結し、
技術者育成プログラムを様々な形で
展開します。
私たちは、臨床検査技師をはじめ医療・健康分野に従事する皆様のスキルアップを目的とした支援サービスを提供しております。
より高い技術やスキルを追求するプロフェッショナルが、忙しい日々のなかでも身近にアクセスできる環境を整えること。
そして、私たちのサービスを通じて、個人・組織が持つ可能性を最大限に引き出し、
医療・健康分野全体の発展に貢献できることを心から願っています。
講座について SERVICE
医療・福祉の現場で必要とされる
技術・知識・経験を
もっと身近な研修環境で。
オンラインの研修システムを通して、検査技術のうち「形態学」にフォーカスした専門講座をどこからでも受講いただける機会を提供しています。今後、より広い領域の研修カリキュラムも企画・リリースしていく計画です。
また、医療施設・企業ごとのオリジナルカリキュラムを作成し実施いたします。
※各カリキュラムのリリース情報および詳細は、当ホームページ「お知らせ」「講座案内」をご確認ください。